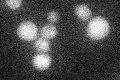
YFL017C
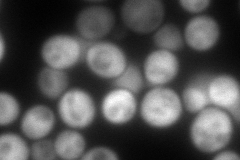
YFL017C
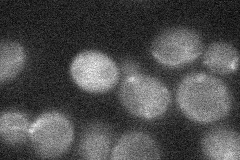
YFL017C
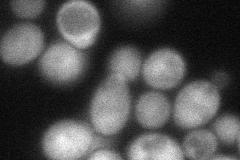
YFL017C
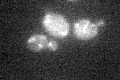
YFL017C
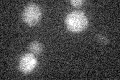
YFL017C

View description
Evolutionarily conserved glucosamine-6-phosphate acetyltransferase required for multiple cell cycle events including passage through START, DNA synthesis, and mitosis; involved in UDP-N-acetylglucosamine synthesis, forms GlcNAc6P from AcCoA
Localization:
Intensity:
Fold change:
Significance:
-
C’ GFP library in SD
below threshold17.7 -
N' NOP1pr-GFP in SD

cytosol0 -
N' TEF2pr-mCherry in SD
cytosol240.135 -
N' NATIVEpr-GFP in SD
cytosol20.151 -
N' TEF2pr-VC and Cyto-VN in SD
cytosol68.6348 -
C’ GFP library in SD+DTT

cytosol16.520.93No -
C’ GFP library in SD+H2O2
cytosol17.380.98No -
C’ GFP library in Starvation Media
cytosol15.950.9No -
C’ GFP library on the background of Pup2-DaMP

below threshold -
C’ GFP library on the background of CCT mutant

below threshold18.43251.04085No
